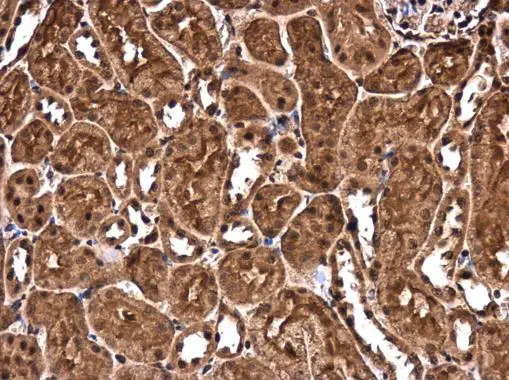
CHD3 antibody detects CHD3 protein at cytoplasm and nucleus in mouse kidney by immunohistochemical analysis. Sample: Paraffin-embedded mouse kidney. CHD3 antibody (GTX131779) diluted at 1:500. 
 Antigen Retrieval: Citrate buffer, pH 6.0, 15 min

CHD3 antibody detects CHD3 protein at cytoplasm and nucleus by immunofluorescent analysis. Sample: HeLa cells were fixed in 4% paraformaldehyde at RT for 15 min. Green: CHD3 protein stained by CHD3 antibody (GTX131779) diluted at 1:500. Blue: Hoechst 33342 staining.
CHD3 antibody
GTX131779
ApplicationsImmunoFluorescence, Western Blot, ImmunoCytoChemistry, ImmunoHistoChemistry, ImmunoHistoChemistry Paraffin
Product group Antibodies
ReactivityHuman, Mouse
TargetCHD3
Overview
- SupplierGeneTex
- Product NameCHD3 antibody
- Delivery Days Customer9
- Application Supplier NoteWB: 1:500-1:3000. ICC/IF: 1:100-1:1000. IHC-P: 1:100-1:1000. *Optimal dilutions/concentrations should be determined by the researcher.Not tested in other applications.
- ApplicationsImmunoFluorescence, Western Blot, ImmunoCytoChemistry, ImmunoHistoChemistry, ImmunoHistoChemistry Paraffin
- CertificationResearch Use Only
- ClonalityPolyclonal
- Concentration0.76 mg/ml
- ConjugateUnconjugated
- Gene ID1107
- Target nameCHD3
- Target descriptionchromodomain helicase DNA binding protein 3
- Target synonymsMi-2a, Mi2-ALPHA, SNIBCPS, ZFH, chromodomain-helicase-DNA-binding protein 3, ATP-dependent helicase CHD3, CHD-3, hZFH, mi-2 autoantigen 240 kDa protein, zinc finger helicase, zinc-finger helicase (Snf2-like)
- HostRabbit
- IsotypeIgG
- Protein IDQ12873
- Protein NameChromodomain-helicase-DNA-binding protein 3
- Scientific DescriptionThis gene encodes a member of the CHD family of proteins which are characterized by the presence of chromo (chromatin organization modifier) domains and SNF2-related helicase/ATPase domains. This protein is one of the components of a histone deacetylase complex referred to as the Mi-2/NuRD complex which participates in the remodeling of chromatin by deacetylating histones. Chromatin remodeling is essential for many processes including transcription. Autoantibodies against this protein are found in a subset of patients with dermatomyositis. Three alternatively spliced transcripts encoding different isoforms have been described. [provided by RefSeq]
- ReactivityHuman, Mouse
- Storage Instruction-20°C or -80°C,2°C to 8°C
- UNSPSC12352203
References
- McMahon KA, Stroud DA, Gambin Y, et al. Cavin3 released from caveolae interacts with BRCA1 to regulate the cellular stress response. Elife. 2021,10. doi: 10.7554/eLife.61407Read this paper

![ICC/IF analysis of HeLa cells using GTX83232 CHD3 antibody [2G4]. Green : CHD3 Blue: DRAQ5 fluorescent DNA dye](https://www.genetex.com/upload/website/prouct_img/normal/GTX83232/GTX83232_20170912_ICCIF_w_23061322_530.webp)

